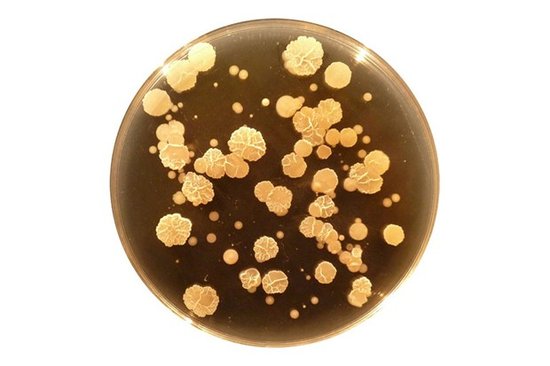

研究人员称肚脐生态系统中的细菌分布有点类似于热带雨林的树木分布
腾讯科学讯(过客/编译)生物学家的研究结果表明一个超过2300个细菌物种组成的微生物多样性“丛林”出现而且只有其中的8种频繁出现,非常类似于热带雨林中树木物种的多样性分布。肚脐生物多样性项目开始把生活作为吸引公众参与个人科学研究的一种方法,通过培养肚脐细菌来来提供一种个人的微生物肖像。培养上的显著差异鼓励研究人员们扩展了这个项目并且进一步探索肚脐和细菌数据。
北卡罗来纳州大学公共科学系的主人霍利-梅宁格说道:“我们就像探险家面对一个新发现的雨林地带一样从首批66个肚脐眼收集数据。我们从很基本的问题开始,换句话说就是什么种类以及有多少种类生活在肚脐眼中。”这些种类的分布可以用“寡头”进行最好的解释,这些种类存在于大多数的生态系统中。
这个项目的首席生物学家罗伯-邓恩在《科学美国人》的一篇博客上说道:“相反的是,罕见的种类趋向于一直稀少。即使我们不能预言你拥有什么细菌种类,但是我们能够预言哪些种类毫无疑问很可能存在。”
样本数据中少量种类出现的丰富度和频率让研究团队推断这种调整适应于营养贫乏的细菌群体似乎有点不成比例。假如你想知道个人水平是什么结果的话,你自己的肚脐含有大约67种细菌种类,然而研究并未提供任何确定那些细菌或许是什么种类的方法。这个项目不再接受肚脐样本,一个探索腋窝生物多样性的姐妹项目也可能在不久的将来寻找参与者。
编辑:sayaliu
新闻来源:http://tech.qq.com/a/20121110/000040.htm

留言